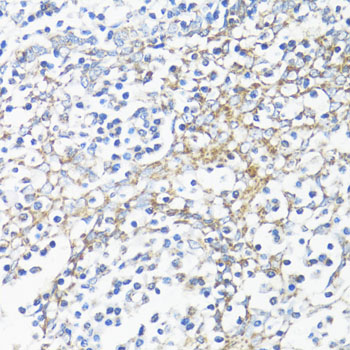
Immunohistochemistry - HSD17B10 Polyclonal Antibody

-
Product Name
HSD17B10 Polyclonal Antibody
- Documents
-
Description
Polyclonal antibody to HSD17B10
-
Tested applications
WB, IHC, IF
-
Species reactivity
Human, Mouse, Rat
-
Alternative names
HSD17B10 antibody; 17b-HSD10 antibody; ABAD antibody; CAMR antibody; DUPXp11.22 antibody; ERAB antibody; HADH2 antibody; HCD2 antibody; MHBD antibody; MRPP2 antibody; MRX17 antibody; MRX31 antibody; MRXS10 antibody; SCHAD antibody; SDR5C1 antibody; HSD10MD antibody; 3-hydroxyacyl-CoA dehydrogenase type-2 antibody
-
Isotype
Rabbit IgG
-
Preparation
Antigen: Recombinant fusion protein containing a sequence corresponding to amino acids 1-261 of human HSD17B10 (NP_004484.1).
-
Clonality
Polyclonal
-
Formulation
PBS with 0.02% sodium azide, 50% glycerol, pH7.3.
-
Storage instructions
Store at -20℃. Avoid freeze / thaw cycles.
-
Applications
WB 1:500 - 1:2000
IHC 1:50 - 1:100
IF 1:50 - 1:100 -
Validations

Western blot - HSD17B10 Polyclonal Antibody
Western blot analysis of extracts of various cell lines, using HSD17B10 antibody at 1:1000 dilution.Secondary antibody: HRP Goat Anti-Rabbit IgG (H+L) at 1:10000 dilution.Lysates/proteins: 25ug per lane.Blocking buffer: 3% nonfat dry milk in TBST.Detection: ECL Basic Kit .Exposure time: 30s.
Immunohistochemistry - HSD17B10 Polyclonal Antibody
Immunohistochemistry of paraffin-embedded human tonsil using HSD17B10 antibody at dilution of 1:100 (40x lens).

Immunohistochemistry - HSD17B10 Polyclonal Antibody
Immunohistochemistry of paraffin-embedded human liver cancer using HSD17B10 antibody at dilution of 1:100 (40x lens).

Immunohistochemistry - HSD17B10 Polyclonal Antibody
Immunohistochemistry of paraffin-embedded human colon using HSD17B10 antibody at dilution of 1:100 (40x lens).
-
Background
Mitochondrial dehydrogenase that catalyzes the beta-oxidation at position 17 of androgens and estrogens and has 3-alpha-hydroxysteroid dehydrogenase activity with androsterone. Catalyzes the third step in the beta-oxidation of fatty acids. Carries out oxidative conversions of 7-alpha-OH and 7-beta-OH bile acids. Also exhibits 20-beta-OH and 21-OH dehydrogenase activities with C21 steroids. By interacting with intracellular amyloid-beta, it may contribute to the neuronal dysfunction associated with Alzheimer disease (AD). Essential for structural and functional integrity of mitochondria.; In addition to mitochondrial dehydrogenase activity, moonlights as a component of mitochondrial ribonuclease P, a complex that cleaves tRNA molecules in their 5'-ends. Together with HSD17B10/MRPP2, forms a subcomplex of the mitochondrial ribonuclease P, named MRPP1-MRPP2 subcomplex, which displays functions that are independent of the ribonuclease P activity. The MRPP1-MRPP2 subcomplex catalyzes the formation of N(1)-methylguanine and N(1)-methyladenine at position 9 (m1G9 and m1A9, respectively) in tRNAs; HSD17B10/MRPP2 acting as a non-catalytic subunit. The MRPP1-MRPP2 subcomplex also acts as a tRNA maturation platform: following 5'-end cleavage by the mitochondrial ribonuclease P complex, the MRPP1-MRPP2 subcomplex enhances the efficiency of 3'-processing catalyzed by ELAC2, retains the tRNA product after ELAC2 processing and presents the nascent tRNA to the mitochondrial CCA tRNA nucleotidyltransferase TRNT1 enzyme.
Related Products / Services
Please note: All products are "FOR RESEARCH USE ONLY AND ARE NOT INTENDED FOR DIAGNOSTIC OR THERAPEUTIC USE"
